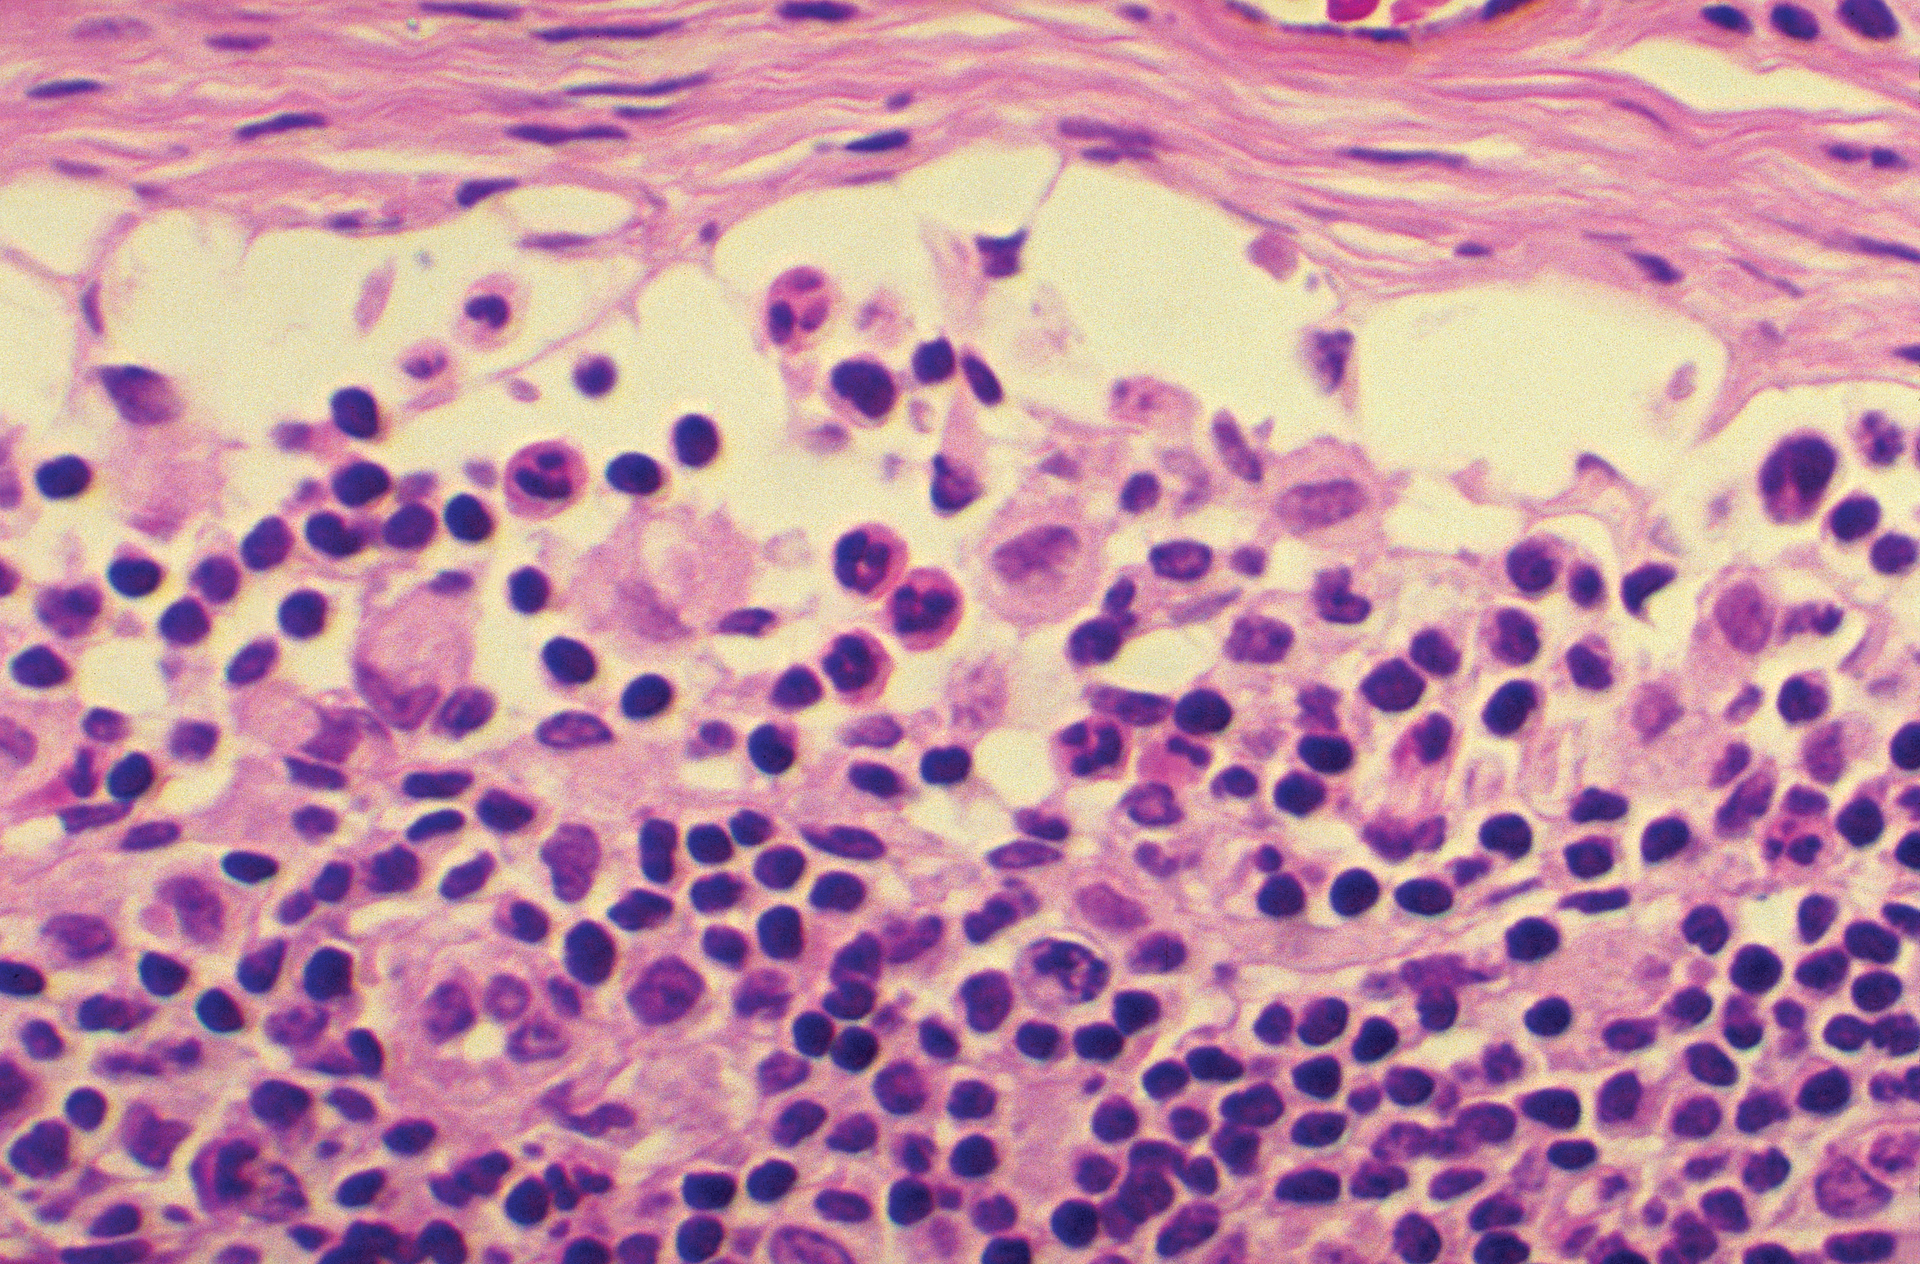
Cdc Hiv 61e06be5769a3

COVID-19 and HIV co-infection: The importance of vigilant and advanced detection and diagnostic capabilities
Since the World Health Organization (WHO) officially announced the coronavirus (COVID-19) outbreak as a pandemic on March 11, 2020, severe acute respiratory syndrome coronavirus 2 (SARS-CoV-2) has continued to present a global challenge. Healthcare systems are still under immense pressure in many regions as some countries continue to battle severe waves of the virus. Globally, as of November 9, 2021, there have been 250,154,972 confirmed cases of COVID-19, including 5,054,267 deaths, reported to WHO. As of November 8, 2021, a total of 7,084,922,999 vaccine doses have been administered.1
The global effort to contain COVID-19 has resulted in extraordinary and unprecedented worldwide collaborative efforts from healthcare workers, researchers, industry bodies, and governments. The scientific community continues to respond to the ongoing threat of COVID-19 by learning as much as possible about how the disease spreads, how it affects people and communities, the long-term impact on the body after infection, and the incidence of concomitant infection with other pathogens.
However, as COVID-19 has a variety of clinical manifestations, it may be challenging to distinguish co-infections which share clinical features, such as human immunodeficiency virus (HIV). It’s vitally important to quickly detect co-infection in COVID-19 patients with HIV and accurately identify causative pathogens to deliver effective treatment.
COVID-19 research developments
An increasing amount of research is uncovering the true impact of secondary bacterial, fungal, and viral infections in COVID-19 patients. Microbiologists, epidemiologists, virologists, and pathologists have generated vast bodies of research investigating the structure of SARS-CoV-2, its mechanism of infection, the COVID-19 disease pathway and how it affects individuals differently, studying the long-term effects of COVID-19 and, more recently, studying and tracking mutations that could lead to new viral variants.
Another important but complex area of research is SARS-CoV-2 co-infection, where an individual may be infected with the virus and one or more additional pathogens concomitantly. SARS-CoV-2 infection leads to both innate and adaptive immune responses, which, in some cases of severe disease, can become dysfunctional and cause significant lung and systemic pathology. 2 This lung damage and dysregulated immune response in severe COVID-19 pneumonia puts these patients at an increased risk of secondary infection. In addition, individuals with pre-existing conditions could be more susceptible to severe COVID-19 disease if infected.
Rapid diagnosis is critical to identifying and diagnosing such infections and determining the correct course of treatment, as quickly as possible. However, several factors can complicate patient diagnosis and treatment in the case of co-infection. Secondary infection could be more easily missed and go undiagnosed in the face of a SARS-CoV-2 primary infection, especially if symptoms overlap. Diligent testing of COVID-19 patients for other infectious diseases is, therefore, vital. Importantly, patients with severe COVID-19 disease in intensive care units (ICUs) are at increased risk of nosocomial infection and should be carefully monitored as rapid treatment decisions are required, particularly in the case of multi-drug-resistant (MDR) microorganisms.
COVID-19 outcomes for patients with HIV
Although the reported incidence of bacterial, fungal, and viral co-infections in hospitalized COVID-19 patients is relatively low 3 when present, they may cause severe diseases with poorer outcomes. For example, many studies have reported a higher incidence of secondary infections in patients admitted to the ICU,4,5 and those diagnosed with secondary infections had lower discharge rates and higher mortality rates than those without secondary infection.6 Researchers are still looking to determine whether this outcome is a function of longer ICU stays, concomitantly administered medications (e.g., antibiotics, immunomodulators), the immunocompromising effects of severe COVID-19 itself, or other factors.7
People living with HIV (PLHIV) who have a compromised immune system, including those with a low CD4 count or high viral load, may be less able to cope with infectious diseases, such as COVID-19 and any bacterial or fungal co-infections. However, the rate of COVID-19/HIV co-infection and impact on patient outcomes is not clear, and reports differ over morbidity and mortality rates. Studies are often limited by small patient groups — many including a single case report of HIV co-infection — and results depend heavily on HIV epidemiology in specific geographies.
For example, one study of a cohort of patients from Western Cape Province, South Africa, reported that HIV was associated with a doubling of COVID-19 mortality risk,8 whereas a systemic literature review found that PLHIV is largely affected by similar features of disease risk and progression as those without HIV,9 and studies from the UK,10 Germany,11 and the United States12 report no excess morbidity or mortality in HIV patients.
Researchers are also working to understand the impact of tuberculosis and HIV co-infected patients on COVID-19 pathogenesis. The interaction between TB and HIV has been extensively studied: without ART, the risk of latent TB infection progressing to active TB disease in PLHIV is greater than in immunocompetent individuals.13 In addition, management of MDR TB in people living with HIV is complicated by higher rates of drug toxicities that may be exacerbated in the setting of COVID-19 co-infection.14
HIV drug resistance (HIVDR) is a growing concern that, if not addressed, could jeopardize the successful scale up of ART that has been seen in recent years. An increased incidence of HIVDR could limit the possible protection that antiretroviral drugs afford HIV patients infected with COVID-19.
Viral load testing
According to European Union (EU) recommendations, timely and accurate COVID-19 laboratory testing is an essential part of the management of COVID-19. Testing helps fight the pandemic, supports decisions on infection control strategies and patient management at healthcare facilities, and detects asymptomatic cases that could spread the virus further, if not isolated. Early testing, diagnosis, and intervention significantly increase the likelihood of an individual’s recovery — where a gain in minutes or hours can mean the difference between life and death. Reducing the need for prolonged and often invasive ICU treatment, the chance of recovery is greater and vital resources are available more quickly for the next patient.
A swift and accurate diagnosis establishes the correct course of action straight away, which ultimately means fewer lives will be lost. Fast and simple HIV viral load testing is needed to appropriately monitor HIV patients and ensure ART programs are followed to minimize comorbidity with COVID-19.
With clinical laboratories across the globe under intense pressure to deliver increased demand for test results, advances in molecular and diagnostic systems offer a rapid response. Modern real-time PCR kits are designed to improve rapid, targeted results in clinical areas that suffer from poor culture sensitivity, or where organism growth rate has an impact on clinical care and health economic outcomes. Results from real-time PCR are used together with clinical patient observations to provide a clearer picture of the infectious disease etiology, diagnosis, and the best course of treatment.
Clinical microbiology solutions are key for early identification of bacterial or fungal diseases that can affect COVID-19 patients with weakened immune systems, such as those who may be also suffering from HIV or related complications. A next-generation PCR thermal cycler and reader, together with assays, can enable fast HIV viral load testing to facilitate successful ART. By using the same automated extraction protocol as COVID-19 assays, labs can quickly implement these assays with minimal training.
Future considerations
The volume of literature surrounding COVID-19 research continues to grow at a significant pace, as the scientific community endeavors to deepen its knowledge of the virus’ epidemiology, understand public health and mental health impacts, gather data on hospital mortality, and develop better diagnostics and therapies. In addition, more research is unfolding to better understand the challenges of diagnosing and managing co-infections, such as HIV/AIDS.
However, research remains in the early stages, and there is not yet a clear picture of how co-infection impacts clinical outcomes or if existing infections predispose individuals to poorer COVID-19 resilience. Rapidly identifying secondary pathogens, and diagnosing such co-infections, is vital to determining the correct course of treatment and improving patient outcomes. Microbial detection and identification tools are not only contributing to research discoveries but allow clinical microbiologists to make fast and well-informed treatment decisions that, for critically ill COVID-19 patients, can make all the difference.
References
- World Health Organization. WHO coronavirus (COVID-19) dashboard. November 9, 2021. [Online]. https://covid19.who.int/. Accessed December 28, 2021.
- Tay M, Poh C, Rénia L, et al. The trinity of COVID-19: Immunity, inflammation, and intervention. Nat Rev Immunol. 2020; 20: 363-374. doi: 10.1038/s41577-020-0311-8.
- Rawson T, Wilson R, Holmes A. Understanding the role of bacterial and fungal infection in COVID-19. Clinical Microbiology and Infection. 2021; 27: 9-11. doi: 10.1016/j.cmi.2020.09.025.
- Ripa M, Galli L, Poli A, et al. Secondary infections in patients hospitalized with COVID-19: incidence and predictive factors. Clin Microbiol Infect. 2021; 27(3). doi: 10.1016/j.cmi.2020.10.021.
- Bardi T, Pintado V, Gomez-Rojo M, et al. Nosocomial infections associated to COVID-19 in the intensive care unit: clinical characteristics and outcome. Eur J Clin Microbiol Infect Dis. 2021; 40: 495-502. doi: 10.1007/s10096-020-04142-w.
- Zhang H, Zhang Y, Wu J, et al. Risks and features of secondary infections in severe and critical ill COVID-19 patients. Emerging Microbes & Infections. 2020; 9(1):1958-1964. doi: 10.1080/22221751.2020.1812437.
- Glück T. Secondary Infections in Patients with Severe COVID-10. NEJM Journal Watch. 2021.
- Davies M. HIV and risk of COVID-19 death: a population cohort study from the Western Cape Province, South Africa. medRxiv. July 2020. doi.org/10.1101/2020.07.02.20145185.
- Mirzaei H, McFarland W, Karamouzian M, et al. COVID-19 among people living with HIV: A systematic review. AIDS Behav. 2021; 25: 85-92. doi: 10.1007/s10461-020-02983-2.
- Toombs J, Van den Abbeele K, Democratis J, et al. Letter to the Editor: COVID-19 in three people living with HIV in the United. J Med Virol. 2020; 93(3):107-109. doi: 10.1002/jmv.26178.
- Härter G, Spinner C, Roider J, et al. COVID-19 in people living with human immunodeficiency virus: a case series of 33 patients. Infection. 2020; 70 (4): 643-652. doi: 10.1007/s15010-020-01438-z.
- Ridgway J, Farley B, Benoit J, et al. A case series of five people living with HIV hospitalized with COVID-19 in Chicago, Illinois. AIDS Patient Care STDS, 2020 Aug;34(8):331-335. doi: 10.1089/apc.2020.0103.
- Ong C, G. Migliori B, Raviglione M, et al. Epidemic and pandemic viral infections: impact on tuberculosis and the lung. Eur Respir J. 2020; 56(4): 2001727. doi: 10.1183/13993003.01727-2020.
- Vilbrun S, Mathurin L, Pape J. Case report: Multidrug-resistant tuberculosis and COVID-19 coinfection in Port-au-Prince, Haiti. Am. J. Trop. Med. Hyg. 2020;103(5):1986-1988. doi: 10.4269/ajtmh.20-0851.
About the Author

Marc Tordjeman, PhD
started Biocentric, a French Biotech company that is now part of Bruker Microbiology and Diagnostics. In 2005, resulting from a collaborative work with the French National AIDS Research Agency (ANRS), a commercial, reliable, and affordable HIV viral load on open PCR platform was launched with the objective to give low resource-countries access to HIV viral load.